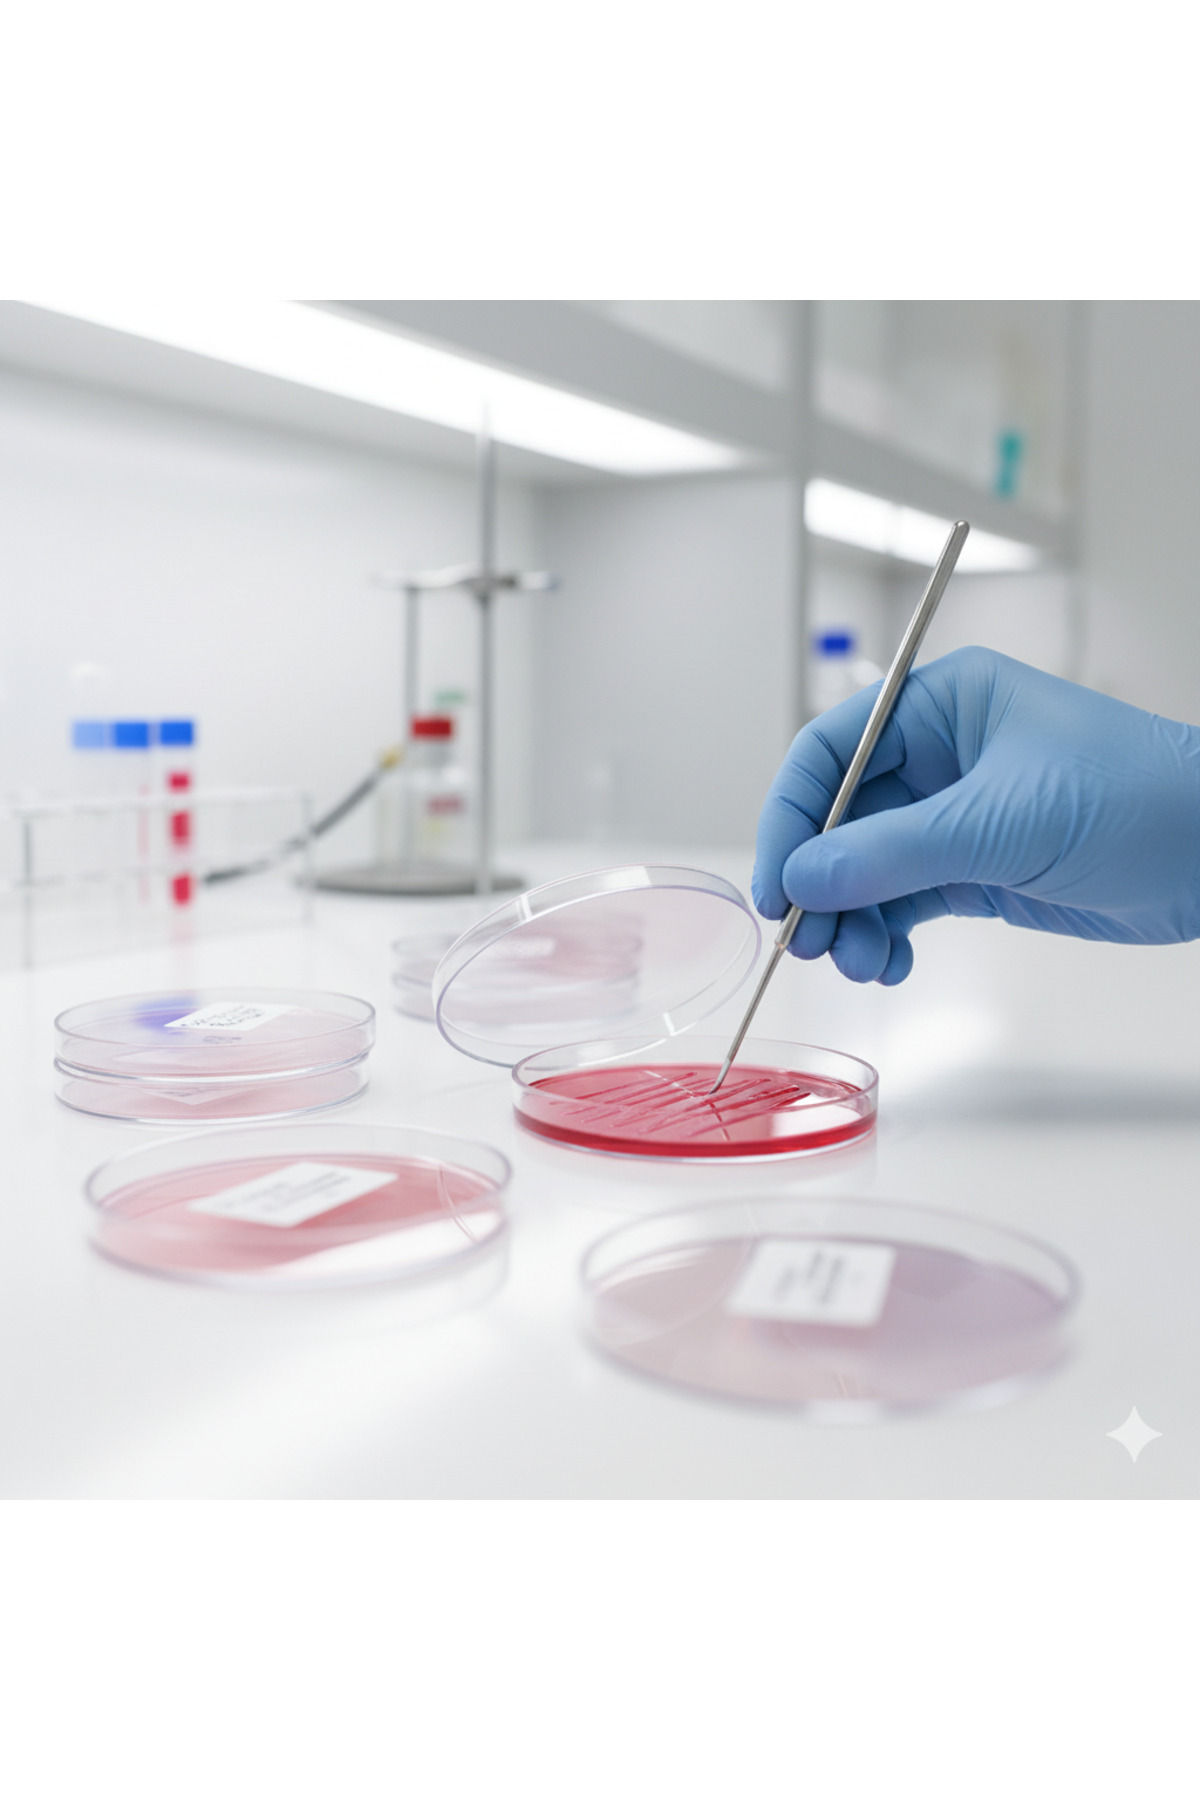

25 ADET 90 MM PETRİ KABI - - ASEPTİK STERİL
(0
المراجعات)
تم بيعها من قبل
craftenshop ( TR )
السعر
39.08 LYD
/unit
شارك

- Kampanya fiyatından satılmak üzere 100 adetten fazla stok sunulmuştur.
- İncelemiş olduğunuz ürünün satış fiyatını satıcı belirlemektedir.
- Bir ürün, birden fazla satıcı tarafından satılabilir. Birden fazla satıcı tarafından satışa sunulan ürünlerin satıcıları ürün için belirledikleri fiyata, satıcı puanlarına, teslimat statülerine, ürünlerdeki promosyonlara, kargonun bedava olup olmamasına ve ürünlerin hızlı teslimat ile teslim edilip edilememesine, ürünlerin stok ve kategorileri bilgilerine göre sıralanmaktadır.
- - 25 adet 90 mm boyutunda, sterilize edilmiş Petri kabı seti, laboratuvar çalışmalarınızda güvenilir ve hijyenik bir ortam sağlar.
- - Menşei Türkiye olan bu ürünler, yerel üretimle desteklenerek kaliteli ve güvenilir bir seçenek sunar.
- - FIRATMED markası tarafından üretilen bu Petri kabı seti, yüksek kalite standartlarına uygun olarak tasarlanmıştır.
- - Her bir kabın sterilizasyon süreci, mikroorganizmaların büyümesi için ideal koşullar yaratırken, çalışmalarınızın doğruluğunu ve güvenilirliğini artırır.
Menşei
TR
المنتجات المشابهة
Huni Plastik Ø40mm (1 Adet)
14.07 LYD
Kulplu Beher 50 ml
18.07 LYD
Bitkisel Gliserin(VG) 1000 Ml.
46.89 LYD
Dinamometre (10n) 1 Kg
34.36 LYD
PASTÖR PİPET (5ADET)
3.27 LYD
Hidrojen Peroksit %50 - 5 Litre
65.18 LYD
Mezür Cam 1000 ML Altıgen Taban
136.77 LYD
Tri Etanol Amin (Tea) 1 Kg
60.94 LYD






















